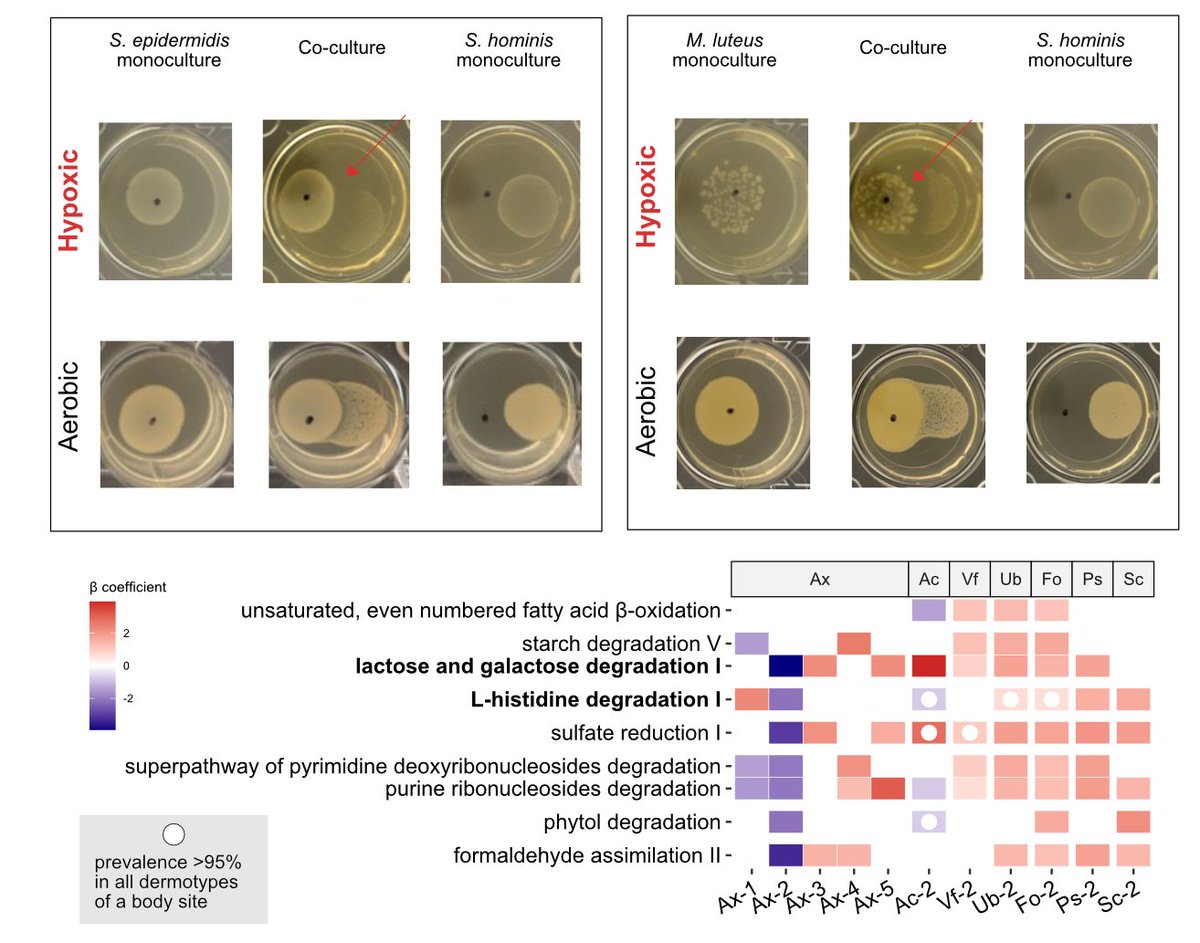
3. Microbes behave very differently across dermotypes in terms of who they co-occur with! We can confirm this with culture-based experiments that show that oxygen gradients and nutrient availability likely shape why we see distinct dermotypes in various individuals. <a href="/atVidu/">Viduthalai Rasheedkhan Regina</a>

Cherry Chengchen Li 李成辰
@chengchenlic
PhD student at NUS. Former research project manager & data analyst at Harvard Microbiome Center;Emory-Rollins, UIowa alumni.
ID: 1140974751294377985
18-06-2019 13:29:13
16 Tweet
35 Followers
54 Following












3. Microbes behave very differently across dermotypes in terms of who they co-occur with! We can confirm this with culture-based experiments that show that oxygen gradients and nutrient availability likely shape why we see distinct dermotypes in various individuals. Viduthalai Rasheedkhan Regina

Viduthalai Rasheedkhan Regina 4. Dermotypes exhibit distinct associations w/ host, where ethnicity and gender play a role in some cases, while others are linked to skincare behaviors. Skin sensitivity, itch and eczema may be affected by dermotype function, highlighting utility for patient stratification & Tx


Viduthalai Rasheedkhan Regina 5. Exciting days ahead as we try to decipher the contributions of diverse factors that shape skin microbiome dermotypes, and in turn their influence on skin health!




